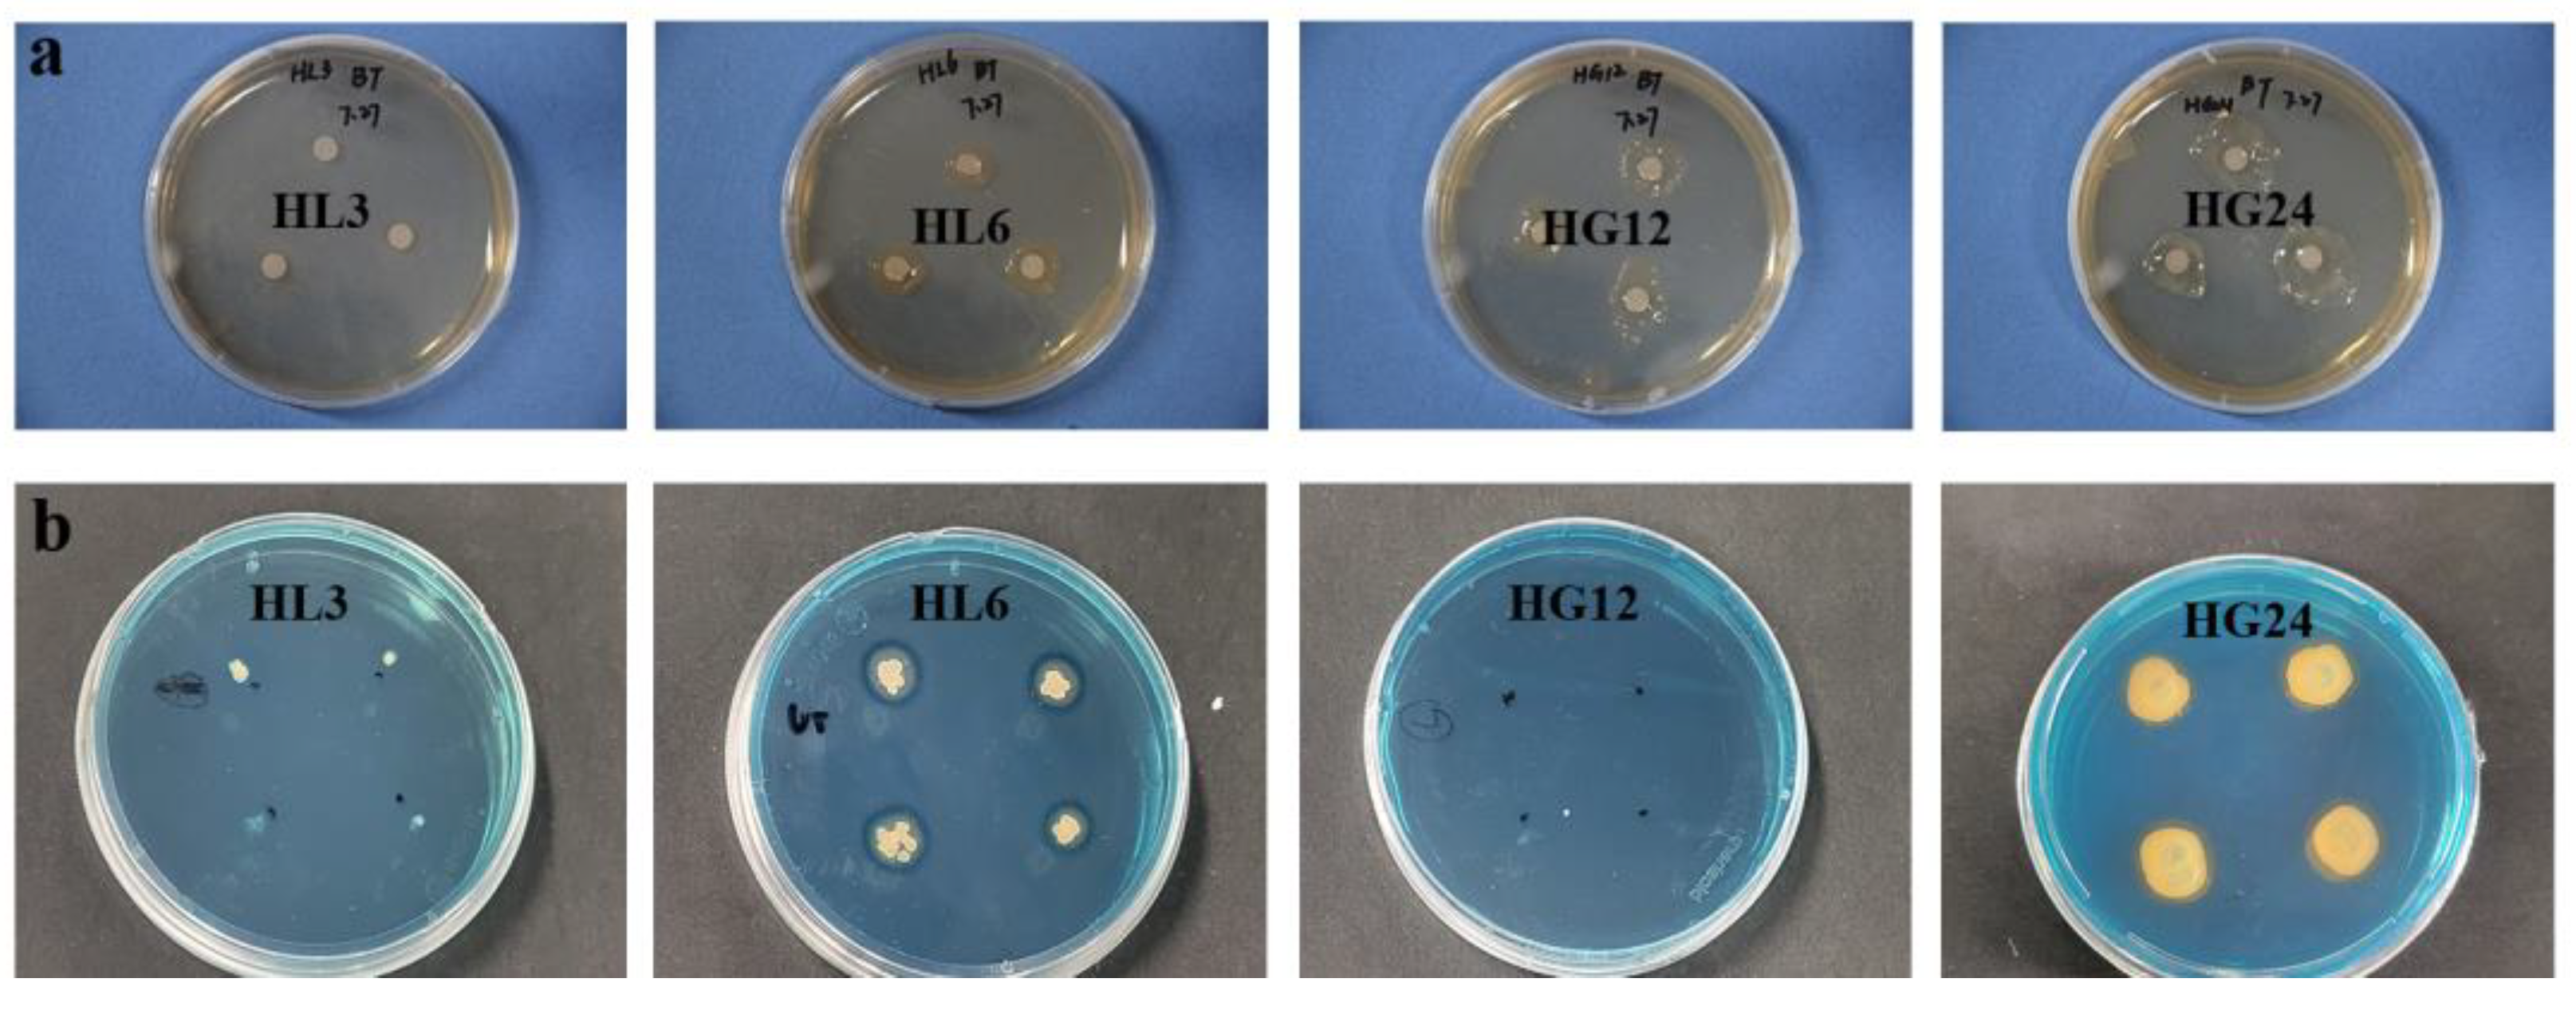
Microorganisms 12 00616 g003

Comparative Analysis of Plant Growth-Promoting Rhizobacteria’s Effects on Alfalfa Growth at the Seedling and Flowering Stages under Salt Stress
Abstract
1. Introduction
2. Materials and Methods
2.1. Isolation and Identification of Selected Strains
2.2. Salt Tolerance of Selected Strains
2.3. Qualitative Determination of Plant Growth-Promoting Characteristics of Selected Strains
2.4. Quantitative Determination of Plant Growth-Promoting Characteristics of Selected Strains
2.5. The Effect of Selected Strains on the Growth of Alfalfa in Saline Soil
2.5.1. Preparation of Bacterial Inocula
2.5.2. Pot Experiment
2.5.3. Plant Growth and Biomass
2.5.4. Proline Content
2.5.5. Membrane Stability Index
2.6. Statistical Analysis
3. Results
3.1. Identification and Salt-Drought Tolerance of Selected Strains
3.2. Plant Growth-Promoting Traits of Selected Strains
3.2.1. Qualitative Analysis
3.2.2. Quantitative Analysis
3.3. Effects of Inoculation with Selected Strains on Alfalfa Growth
4. Discussion
4.1. Inconsistencies in Strain Characteristic Analysis between Qualitative Testing and Quantitative Testing
4.2. Significant Inhibition of IAA Production Characteristics in Strains under Salt Stress Compared to Other Growth-Promoting Traits
4.3. The Varied Role of Selected Strains at Different Growth Stages of Alfalfa
5. Conclusions
Supplementary Materials
Author Contributions
Funding
Data Availability Statement
Conflicts of Interest
Correction Statement
References
- Yang, J.; Zhao, J.; Zhu, G.; Wang, Y.; Ma, X.; Wang, J.; Guo, H.; Zhang, Y. Soil salinization in the oasis areas of downstream inland rivers -Case Study: Minqin oasis. Quat. Int. 2020, 537, 69–78. [Google Scholar] [CrossRef]
- Cheng, X.Y.; Guo, C.X.; Li, F.M.; Liu, S.Z.; Zhu, S.J. Cultivation of introduced alfalfa varieties in an arid area of Minqin county. Acta Prataculturae Sin. 2009, 18, 248–253. [Google Scholar]
- Marulanda, A.; Barea, J.-M.; Azcón, R. Stimulation of Plant Growth and Drought Tolerance by Native Microorganisms (AM Fungi and Bacteria) from Dry Environments: Mechanisms Related to Bacterial Effectiveness. J. Plant Growth Regul. 2009, 28, 115–124. [Google Scholar] [CrossRef]
- Fatima, T.; Arora, N.K. Pseudomonas entomophila PE3 and its exopolysaccharides as biostimulants for enhancing growth, yield and tolerance responses of sunflower under saline conditions. Microbiol. Res. 2021, 244, 126671. [Google Scholar] [CrossRef] [PubMed]
- Borj, M.A.; Etesami, H.; Alikhani, H.A. Silicon improves the effect of phosphate-solubilizing bacterium and arbuscular mycorrhizal fungus on phosphorus concentration of salinity-stressed alfalfa (Medicago sativa L.). Rhizosphere 2022, 24, 100619. [Google Scholar] [CrossRef]
- Ansari, M.; Shekari, F.; Mohammadi, M.H.; Juhos, K.; Vegvari, G.; Biro, B. Salt-tolerant plant growth-promoting bacteria enhanced salinity tolerance of salt-tolerant alfalfa (Medicago sativa L.) cultivars at high salinity. Acta Physiol. Plant. 2019, 41, 195. [Google Scholar] [CrossRef]
- Etesami, H.; Beattie, G.A. Mining halophytes for plant growth-promoting halotolerant bacteria to enhance the salinity tolerance of non-halophytic crops. Front. Microbiol. 2018, 9, 148. [Google Scholar] [CrossRef]
- Amna; Din, B.U.; Sarfraz, S.; Xia, Y.; Kamran, M.A.; Javed, M.T.; Sultan, T.; Munis, M.F.H.; Chaudhary, H.J. Mechanistic elucidation of germination potential and growth of wheat inoculated with exopolysaccharide and ACC-deaminase producing Bacillus strains under induced salinity stress. Ecotox. Environ. Safe. 2019, 183, 109466. [Google Scholar] [CrossRef]
- Panwar, M.; Tewari, R.; Nayyar, H. Native halo-tolerant plant growth promoting rhizobacteria Enterococcus and Pantoea sp improve seed yield of Mungbean (Vigna radiata L.) under soil salinity by reducing sodium uptake and stress injury. Physiol. Mol. Biol. Plants 2016, 22, 445–459. [Google Scholar] [CrossRef]
- Baha, N. Impact of bio-fertilizers on germination and early seedling growth of Alfalfa (Medicago sativa L.) under salt stress. Acta Physiol. Plant. 2021, 43, 81. [Google Scholar] [CrossRef]
- Baha, N.; Bekki, A. An approach of improving plant salt tolerance of lucerne (Medicago sativa) grown under salt stress: Use of bio-inoculants. J. Plant Growth Regul. 2015, 34, 169–182. [Google Scholar] [CrossRef]
- Gao, H.; Yang, D.; Yang, L.; Han, S.; Liu, G.; Tang, L.; Chen, J.; Wang, D.; Guo, C. Co-inoculation with Sinorhizobium meliloti and Enterobacter ludwigii improves the yield, nodulation, and quality of alfalfa (Medicago sativa L.) under saline-alkali environments. Ind. Crops Prod. 2023, 199, 116818. [Google Scholar] [CrossRef]
- Noori, F.; Etesami, H.; Zarini, H.N.; Khoshkholgh-Sima, N.A.; Salekdeh, G.H.; Alishahi, F. Mining alfalfa (Medicago sativa L.) nodules for salinity tolerant non-rhizobial bacteria to improve growth of alfalfa under salinity stress. Ecotoxicol. Environ. Saf. 2018, 162, 129–138. [Google Scholar] [CrossRef]
- Liu, J.; Tang, L.; Gao, H.; Zhang, M.; Guo, C. Enhancement of alfalfa yield and quality by plant growth-promoting rhizobacteria under saline-alkali conditions. J. Sci. Food Agric. 2019, 99, 281–289. [Google Scholar] [CrossRef]
- Rafique, A.; Amin, A.; Latif, Z. Screening and characterization of mercury-resistant nitrogen fixing bacteria and their use as biofertilizers and for mercury bioremediation. Pak. J. Zool. 2015, 47, 1271–1277. [Google Scholar]
- Wang, Y.; Yang, C.D.; Yao, Y.L.; Wang, Y.Q.; Zhang, Z.F.; Xue, L. The diversity and potential function of endophytic bacteria isolated from Kobreasia capillifolia at alpine grasslands on the Tibetan Plateau, China. J. Integr. Agric. 2016, 15, 2153–2162. [Google Scholar] [CrossRef]
- Soper, F.M.; Simon, C.; Jauss, V. Measuring nitrogen fixation by the acetylene reduction assay (ARA): Is 3 the magic ratio? Biogeochemistry 2021, 152, 345–351. [Google Scholar] [CrossRef]
- Sumner, J.B. A method for the colorimetric determination of phosphorus. Science 1944, 100, 413–414. [Google Scholar] [CrossRef] [PubMed]
- Ouyang, L.; Pei, H.; Xu, Z. Low nitrogen stress stimulating the indole-3-acetic acid biosynthesis of Serratia sp. ZM is vital for the survival of the bacterium and its plant growth-promoting characteristic. Arch. Microbiol. 2017, 199, 425–432. [Google Scholar] [CrossRef] [PubMed]
- Liu, X.; Chai, J.; Zhang, Y.; Zhang, C.; Lei, Y.; Li, Q.; Yao, T. Halotolerant rhizobacteria mitigate the effects of salinity stress on maize growth by secreting exopolysaccharides. Environ. Exp. Bot. 2022, 204, 105098. [Google Scholar] [CrossRef]
- Kizilkaya, R. Nitrogen fixation capacity of Azotobacter spp. strains isolated from soils in different ecosystems and relationship between them and the microbiological properties of soils. J. Environ. Biol 2009, 30, 73–82. [Google Scholar]
- Liu, B.; Gumpertz, M.L.; Hu, S.; Ristaino, J.B. Long-term effects of organic and synthetic soil fertility amendments on soil microbial communities and the development of southern blight. Soil Biol. Biochem. 2007, 39, 2302–2316. [Google Scholar] [CrossRef]
- Paulo, E.M.; Boffo, E.F.; Branco, A.; Valente, A.; Melo, I.S.; Ferreira, A.G.; Roque, M.R.A.; de Assis, S.A. Production, extraction and characterization of exopolysaccharides produced by the native Leuconostoc pseudomesenteroides R2 strain. An. Acad. Bras. Cienc. 2012, 84, 495–507. [Google Scholar] [CrossRef]
- Arora, N.K.; Verma, M. Modified microplate method for rapid and efficient estimation of siderophore produced by bacteria. 3 Biotech 2017, 7, 381. [Google Scholar] [CrossRef] [PubMed]
- Saidi, S.; Cherif-Silini, H.; Chenari Bouket, A.; Silini, A.; Eshelli, M.; Luptakova, L.; Alenezi, F.N.; Belbahri, L. Improvement of Medicago sativa crops productivity by the co-inoculation of Sinorhizobium meliloti-Actinobacteria Under Salt Stress. Curr. Microbiol. 2021, 78, 1344–1357. [Google Scholar] [CrossRef] [PubMed]
- Zhao, X.; Lin, Q.; Li, B. The Relationship Between Rock Phosphate Solubilization and pH and Organic Acid Production of Microorganisms. J. Microbiol. 2003, 23, 5–7. [Google Scholar]
- Chen, Y.P.; Rekha, P.D.; Arun, A.B.; Shen, F.T.; Lai, W.A.; Young, C.C. Phosphate solubilizing bacteria from subtropical soil and their tricalcium phosphate solubilizing abilities. Appl. Soil Ecol. 2006, 34, 33–41. [Google Scholar] [CrossRef]
- Xie, X.; Liu, Y.; Chen, G.; Turatsinze, A.N.; Yue, L.; Ye, A.; Zhou, Q.; Wang, Y.; Zhang, M.; Zhang, Y.; et al. Granular bacterial inoculant alters the rhizosphere microbiome and soil aggregate fractionation to affect phosphorus fractions and maize growth. Sci. Total Environ. 2024, 912, 169371. [Google Scholar] [CrossRef] [PubMed]
- de Oliveira Mendes, G.; Moreira de Freitas, A.L.; Liparini Pereira, O.; Ribeiro da Silva, I.; Bojkov Vassilev, N.; Dutra Costa, M. Mechanisms of phosphate solubilization by fungal isolates when exposed to different P sources. Ann. Microbiol. 2014, 64, 239–249. [Google Scholar] [CrossRef]
- Patel, D.K.; Archana, G.; Kumar, G.N. Variation in the nature of organic acid secretion and mineral phosphate solubilization by Citrobacter sp. DHRSS in the presence of different sugars. Curr. Microbiol. 2008, 56, 168–174. [Google Scholar] [CrossRef]
- Delvasto, P.; Ballester, A.; Munoz, J.A.; Gonzalez, F.; Blazquez, M.L.; Igual, J.M.; Valverde, A.; Garcia-Balboa, C. Mobilization of phosphorus from iron ore by the bacterium Burkholderia caribensis FeGL03. Miner. Eng. 2009, 22, 1–9. [Google Scholar] [CrossRef]
- Zeng, Q.; Wu, X.; Wen, X. Identification and characterization of the rhizosphere phosphate-solubilizing bacterium Pseudomonas frederiksbergensis JW-SD2, and its plant growth-promoting effects on poplar seedlings. Ann. Microbiol. 2016, 66, 1343–1354. [Google Scholar] [CrossRef]
- Kanse, O.S.; Whitelaw-Weckert, M.; Kadam, T.A.; Bhosale, H.J. Phosphate solubilization by stress-tolerant soil fungus Talaromyces funiculosus SLS8 isolated from the Neem rhizosphere. Ann. Microbiol. 2015, 65, 85–93. [Google Scholar] [CrossRef]
- Adhikari, P.; Pandey, A. Phosphate solubilization potential of endophytic fungi isolated from Taxus wallichiana Zucc. roots. Rhizosphere 2019, 9, 2–9. [Google Scholar] [CrossRef]
- Stefanoni Rubio, P.J.; Godoy, M.S.; Della Mónica, I.F.; Pettinari, M.J.; Godeas, A.M.; Scervino, J.M. Carbon and Nitrogen Sources Influence Tricalcium Phosphate Solubilization and Extracellular Phosphatase Activity by Talaromyces flavus. Curr. Microbiol. 2016, 72, 41–47. [Google Scholar] [CrossRef] [PubMed]
- Zhao, Y.; Zhang, M.; Liu, Z.; Yang, F. Migration and transformation of soil phosphorus by organic acids: A global meta-analysis. J. Soils Sediments 2023, 24, 589–602. [Google Scholar] [CrossRef]
- Rana, A.; Saharan, B.; Joshi, M.; Prasanna, R.; Kumar, K.; Nain, L. Identification of multi-trait PGPR isolates and evaluating their potential as inoculants for wheat. Ann. Microbiol. 2011, 61, 893–900. [Google Scholar] [CrossRef]
- Nautiyal, C.S. An efficient microbiological growth medium for screening phosphate solubilizing microorganisms. FEMS Microbiol. Lett. 1999, 170, 265–270. [Google Scholar] [CrossRef] [PubMed]
- Khan, M.A.; Asaf, S.; Khan, A.L.; Adhikari, A.; Jan, R.; Ali, S.; Imran, M.; Kim, K.M.; Lee, I.J. Plant growth-promoting endophytic bacteria augment growth and salinity tolerance in rice plants. Plant Biol. 2020, 22, 850–862. [Google Scholar] [CrossRef]
- Ashraf, M.; Hasnain, S.; Berge, O.; Mahmood, T. Inoculating wheat seedlings with exopolysaccharide-producing bacteria restricts sodium uptake and stimulates plant growth under salt stress. Biol. Fertil. Soils 2004, 40, 157–162. [Google Scholar] [CrossRef]
- Upadhyay, S.K.; Singh, D.P.; Saikia, R. Genetic diversity of plant growth promoting rhizobacteria isolated from rhizospheric soil of wheat under saline condition. Curr. Microbiol. 2009, 59, 489–496. [Google Scholar] [CrossRef]
- Al-Turki, A.; Murali, M.; Omar, A.F.; Rehan, M.; Sayyed, R.Z. Recent advances in PGPR-mediated resilience toward interactive effects of drought and salt stress in plants. Front. Microbiol. 2023, 14, 1214845. [Google Scholar] [CrossRef] [PubMed]
- Rosa, A.P.; Dias, T.; Mouazen, A.M.; Cruz, C.; Santana, M.M. Finding optimal microorganisms to increase crop productivity and sustainability under drought—A structured reflection. J. Plant Interact. 2023, 18, 2178680. [Google Scholar] [CrossRef]
- Reich, P.B.; Walters, M.B.; Ellsworth, D.S. Leaf life-span in relation to leaf, plant, and stand characteristics among diverse ecosystems. Ecol. Monogr. 1992, 62, 365–392. [Google Scholar] [CrossRef]
- Chen, H.; Huang, Y.; He, K.; Qi, Y.; Li, E.; Jiang, Z.; Sheng, Z.; Li, X. Temporal intraspecific trait variability drives responses of functional diversity to interannual aridity variation in grasslands. Ecol. Evol. 2019, 9, 5731–5742. [Google Scholar] [CrossRef] [PubMed]
- Bashan, Y.; de-Bashan, L.E.; Prabhu, S.R.; Hernandez, J.-P. Advances in plant growth-promoting bacterial inoculant technology: Formulations and practical perspectives (1998–2013). Plant Soil 2014, 378, 1–33. [Google Scholar] [CrossRef]
- George, S.; Minhas, N.M.; Jatoi, S.A.; Siddiqui, S.U.; Ghafoor, A. Impact of polyethylene glycol on proline and membrane stability index for water stress regime in tomato (solanum lycopersicum). Pak. J. Bot. 2015, 47, 835–844. [Google Scholar]
- Kavi Kishor, P.B.; Hima Kumari, P.; Sunita, M.S.L.; Sreenivasulu, N. Role of proline in cell wall synthesis and plant development and its implications in plant ontogeny. Front. Plant Sci. 2015, 6, 00544. [Google Scholar] [CrossRef]
- Ambreen, S.; Athar, H.-u.-R.; Khan, A.; Zafar, Z.U.; Ayyaz, A.; Kalaji, H.M. Seed priming with proline improved photosystem II efficiency and growth of wheat (Triticum aestivum L.). BMC Plant Biol. 2021, 21, 502. [Google Scholar] [CrossRef]
- Penrose, D.M.; Glick, B.R. Methods for isolating and characterizing ACC deaminase-containing plant growth-promoting rhizobacteria. Physiol. Plant. 2003, 118, 10–15. [Google Scholar] [CrossRef]
- Glick, B.R. Bacteria with ACC deaminase can promote plant growth and help to feed the world. Microbiol. Res. 2014, 169, 30–39. [Google Scholar] [CrossRef] [PubMed]
- Dodd, I.C. Abscisic acid and stomatal closure: A hydraulic conductance conundrum? New Phytol. 2013, 197, 6–8. [Google Scholar] [CrossRef] [PubMed]
- Wilkinson, S.; Davies, W.J. Drought, ozone, ABA and ethylene: New insights from cell to plant to community. Plant Cell Environ. 2010, 33, 510–525. [Google Scholar] [CrossRef] [PubMed]
- Wu, H.; Shabala, L.; Azzarello, E.; Huang, Y.; Pandolfi, C.; Su, N.; Wu, Q.; Cai, S.; Bazihizina, N.; Wang, L.; et al. Na+ extrusion from the cytosol and tissue-specific Na+ sequestration in roots confer differential salt stress tolerance between durum and bread wheat. J. Exp. Bot. 2018, 69, 3987–4001. [Google Scholar] [CrossRef]
- Bassil, E.; Blumwald, E. The ins and outs of intracellular ion homeostasis: NHX-type cation/H+ transporters. Curr. Opin. Plant Biol. 2014, 22, 1–6. [Google Scholar] [CrossRef]
- Ryan, M.G.; Phillips, N.; Bond, B.J. The hydraulic limitation hypothesis revisited. Plant Cell Environ. 2006, 29, 367–381. [Google Scholar] [CrossRef]
- Poorter, H.; Niklas, K.J.; Reich, P.B.; Oleksyn, J.; Poot, P.; Mommer, L. Biomass allocation to leaves, stems and roots: Meta-analyses of interspecific variation and environmental control. New Phytol. 2012, 193, 30–50. [Google Scholar] [CrossRef]

| Soil Properties (n = 4) | Value | Irrigation Water Properties | Value |
|---|---|---|---|
| Soil texture | Silt loam (clay: 8.52%; silt: 54.53%; sand: 36.94%) | EC (dS·m−1, n = 3) | 2.09 ± 0.01 |
| ECsoil:water=1:5(dS·m−1) | 0.835 ± 0.038 | TDS (%) | 0.10% |
| pH | 8.47 ± 0.01 | pH (n = 3) | 7.82 ± 0.09 |
| Salt content (%) | 2.73 ± 0.12 | Na+ (mg·L−1, n = 3) | 262.19 ± 1.22 |
| Organic matter (g·kg−1) | 7.26 ± 0.30 | Ca2+ (mg·L−1, n = 3) | 108.01 ± 0.85 |
| Total nitrogen (g·kg−1) | 0.67 ± 0.03 | Ma2+ (mg·L−1, n = 3) | 53.48 ± 0.16 |
| Available nitrogen (mg·kg−1) | 57.06 ± 3.79 | K+ (mg·L−1, n = 3) | 2.57 ± 0.11 |
| Total phosphorus (g·kg−1) | 0.62 ± 0.03 | Cl− (mg·L−1, n = 3) | 272.48 ± 28.88 |
| Available phosphorus (mg·kg−1) | 13.97 ± 0.51 | NO3− (mg·L−1, n = 3) | 5.99 ± 0.44 |
| Available potassium (mg·kg−1) | 99.09 ± 18.71 | SO42− (mg·L−1, n = 3) | 369.59 ± 34.52 |
| Plant Growth-Promoting Traits | HL3 | HL6 | HG12 | HG24 |
|---|---|---|---|---|
| N2 fixation | + | - | + | + |
| Inorganic phosphorus solubilization | + | + | + | + |
| Organic phosphorus solubilization | + | + | + | + |
| IAA production | + | + | + | + |
| EPS production | - | + | + | + |
| Siderophore | - | + | - | + |
Disclaimer/Publisher’s Note: The statements, opinions and data contained in all publications are solely those of the individual author(s) and contributor(s) and not of MDPI and/or the editor(s). MDPI and/or the editor(s) disclaim responsibility for any injury to people or property resulting from any ideas, methods, instructions or products referred to in the content. |
© 2024 by the authors. Licensee MDPI, Basel, Switzerland. This article is an open access article distributed under the terms and conditions of the Creative Commons Attribution (CC BY) license (https://creativecommons.org/licenses/by/4.0/).
Share and Cite
Ma, X.; Huang, C.; Zhang, J.; Pan, J.; Guo, Q.; Yang, H.; Xue, X. Comparative Analysis of Plant Growth-Promoting Rhizobacteria’s Effects on Alfalfa Growth at the Seedling and Flowering Stages under Salt Stress. Microorganisms 2024, 12, 616. https://doi.org/10.3390/microorganisms12030616
Ma X, Huang C, Zhang J, Pan J, Guo Q, Yang H, Xue X. Comparative Analysis of Plant Growth-Promoting Rhizobacteria’s Effects on Alfalfa Growth at the Seedling and Flowering Stages under Salt Stress. Microorganisms. 2024; 12(3):616. https://doi.org/10.3390/microorganisms12030616
Chicago/Turabian StyleMa, Xixi, Cuihua Huang, Jun Zhang, Jing Pan, Qi Guo, Hui Yang, and Xian Xue. 2024. "Comparative Analysis of Plant Growth-Promoting Rhizobacteria’s Effects on Alfalfa Growth at the Seedling and Flowering Stages under Salt Stress" Microorganisms 12, no. 3: 616. https://doi.org/10.3390/microorganisms12030616
APA StyleMa, X., Huang, C., Zhang, J., Pan, J., Guo, Q., Yang, H., & Xue, X. (2024). Comparative Analysis of Plant Growth-Promoting Rhizobacteria’s Effects on Alfalfa Growth at the Seedling and Flowering Stages under Salt Stress. Microorganisms, 12(3), 616. https://doi.org/10.3390/microorganisms12030616

